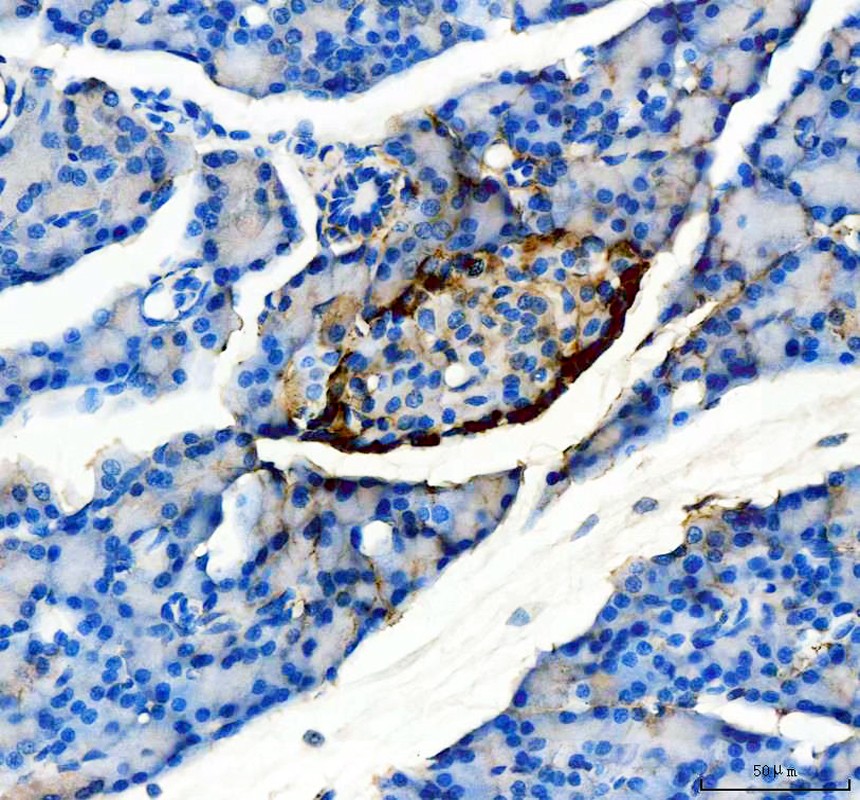

| Immunohistochemistry (IHC): | 1:50-100 |
| Immunofluorescence (IF): | 1:50-100 |

IHC analysis of Glucagon/GCG using anti-Glucagon/GCG antibody (BM1621).
Glucagon/GCG was detected in a paraffin-embedded section of mouse pancrease tissue. The tissue section was incubated with mouse anti-Glucagon/GCG Antibody (BM1621) at a dilution of 1:200 and developed using HRP Conjugated mouse IgG Super Vision Assay Kit (Catalog # SV0001) with DAB (Catalog # AR1027) as the chromogen.

IHC analysis of Glucagon/GCG using anti-Glucagon/GCG antibody (BM1621).
Glucagon/GCG was detected in a paraffin-embedded section of rat pancrease tissue. The tissue section was incubated with mouse anti-Glucagon/GCG Antibody (BM1621) at a dilution of 1:200 and developed using HRP Conjugated mouse IgG Super Vision Assay Kit (Catalog # SV0001) with DAB (Catalog # AR1027) as the chromogen.

IF analysis of Glucagon/GCG using anti-Glucagon/GCG antibody (BM1621).
Glucagon/GCG was detected in a paraffin-embedded section of mouse pancreas tissue. The tissue section was incubated with mouse anti-Glucagon/GCG Antibody (BM1621) at a dilution of 1:100. Dylight594-conjugated Anti-mouse IgG Secondary Antibody (red) (Catalog # BA1141) was used as secondary antibody. The section was counterstained with DAPI (Catalog # AR1176) (Blue).

IHC analysis of Glucagon/GCG using anti-Glucagon/GCG antibody (BM1621).
Glucagon/GCG was detected in a paraffin-embedded section of mouse pancrease tissue. The tissue section was incubated with mouse anti-Glucagon/GCG Antibody (BM1621) at a dilution of 1:200 and developed using HRP Conjugated mouse IgG Super Vision Assay Kit (Catalog # SV0001) with DAB (Catalog # AR1027) as the chromogen.

IHC analysis of Glucagon/GCG using anti-Glucagon/GCG antibody (BM1621).
Glucagon/GCG was detected in a paraffin-embedded section of rat pancrease tissue. The tissue section was incubated with mouse anti-Glucagon/GCG Antibody (BM1621) at a dilution of 1:200 and developed using HRP Conjugated mouse IgG Super Vision Assay Kit (Catalog # SV0001) with DAB (Catalog # AR1027) as the chromogen.

IF analysis of Glucagon/GCG using anti-Glucagon/GCG antibody (BM1621).
Glucagon/GCG was detected in a paraffin-embedded section of mouse pancreas tissue. The tissue section was incubated with mouse anti-Glucagon/GCG Antibody (BM1621) at a dilution of 1:100. Dylight594-conjugated Anti-mouse IgG Secondary Antibody (red) (Catalog # BA1141) was used as secondary antibody. The section was counterstained with DAPI (Catalog # AR1176) (Blue).